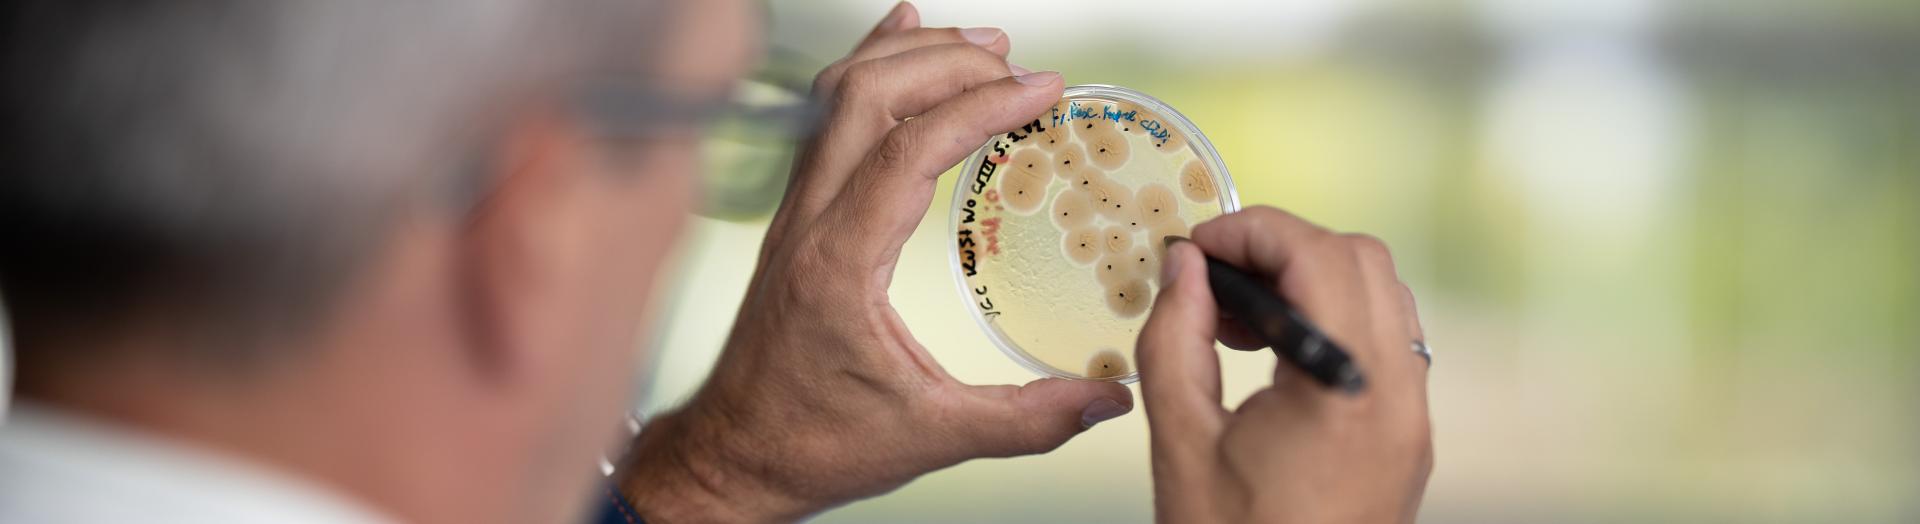
Forscher markiert in Petrischale die wachsende Zellkulturen

Technologie- und Forschungszentrum Wieselburg-Land
Als Aushängeschild des Technologiestandortes Mostviertel widmet sich das TFZ Wieselburg-Land den Themen Bioenergiesysteme sowie Agrar- und Lebensmitteltechnologie.
Namhafte technologie- und forschungsorientierte Unternehmen, die sich mit den Schwerpunkten des Technopol Wieselburg befassen, nutzen die Vorzüge und spezielle Infrastruktur des TFZ Wieselburg-Land. Den angesiedelten Institutionen stehen frei adaptierbare Labor- bzw. Büroflächen zur Verfügung. Der Gebäudekomplex umfasst auch eine geräumige Versuchshalle, die von den Unternehmen vor Ort für ihre Forschungszwecke genutzt werden kann. Das Mietobjekt ist speziell an die Bedürfnisse und Wünsche der Mietenden angepasst - wenn neuer Platzbedarf besteht, ist eine Erweiterung möglich. Eigentümer der TFZ Wieselburg-Land GmbH sind die ecoplus Beteiligungen GmbH (70 %) und die Gemeinde Wieselburg-Land (30 %).

IHR RAUM FÜR FORSCHUNG?
- Gebäudekomplex TFZ Wieselburg-Land in zwei Ausbaustufen errichtet (2009 und 2013)
- freie Labor- und Büroflächen (kleinste Fläche 16 m²) - Erweiterungsmöglichkeiten bei Platzbedarf
- geräumige Versuchshalle - das so genannte "Technikum"
- klimafitte Ausstattung des modernen Gebäudes (mit PV am Dach)
- südlich von Wieselburg, direkt an der B25, Autobahn A1 in 10 Minuten erreichbar
- ausreichend Parkplätze vorhanden
TECHNOPOL WIESELBURG
Wieselburg ist der jüngste Technopolstandort und baut auf die jahrzehntelange Tradition des Agrarraumes Mostviertel in den Bereichen Land- und Forstwirtschaft sowie Landtechnik - insbesondere in den Technologiefeldern:
- Bioenergiesysteme
- Agrartechnologie
- Lebensmitteltechnologie
- Ressource "Wasser" in ökologischer, wirtschaftlicher und medizinischer Hinsicht

Eine Frage des Standorts
6 angesiedelte Unternehmen
6 angesiedelte Unternehmen
2.825 m² Gesamtfläche
2.825 m² Gesamtfläche
246 m² freie Fläche
246 m² freie Fläche
91 % Auslastung
der Immobilie
91 % Auslastung
der Immobilie

Regionales Wirtschaftszentrum
- zentrale Lage im Bezirk Scheibbs im Mostviertel
- anerkannte Institutionen und Unternehmen in der näheren Umgebung - beispielsweise ZKW, FH Wiener Neustadt Campus Wieselburg, Francisco Josephinum, LMTZ und Schloss Weinzierl
- Wieselburg als Wirtschaftszentrum der Region mit zahlreichen KMU, gastronomischen Einrichtungen und Beherbergungsbetrieben
- Messe-, Schul- und Braustadt (Brauerei Wieselburg) mit reichen Kulturschätzen
Gebündelte Kompetenz
Im TFZ Wieselburg-Land ist die Kompetenz namhafter forschungsaffiner Unternehmen versammelt. Ein Mieter der ersten Stunden ist das Kompetenzzentrum BEST (Bioenergy- and Sustainable Technologies GmbH), eine weltweit anerkannte Forschungsgruppe für die Bereiche Bioenergie, Energieeffizienz und erneuerbare Energien. Als K1 Kompetenzzentrum des COMET Programms füllt es die Lücke zwischen akademischer Forschung und Technologieentwicklung.
In Wieselburg ist nicht nur Kultur und Kulinarik zu finden, sondern es bietet auch Ausbildungsstätten und Industriebetriebe.
IHR KONTAKT ZUM ERFOLG

Peter Haselmayer
TFZ - Technologie- und Forschungszentrum Wieselburg-Land GmbH
Gewerbepark Haag 3
3250 Wieselburg, Österreich
Firmenbuchnummer: FN 310496 m beim LG St. Pölten
UID Nummer: ATU64398208
Koordinaten: 48.116489, 15.135998